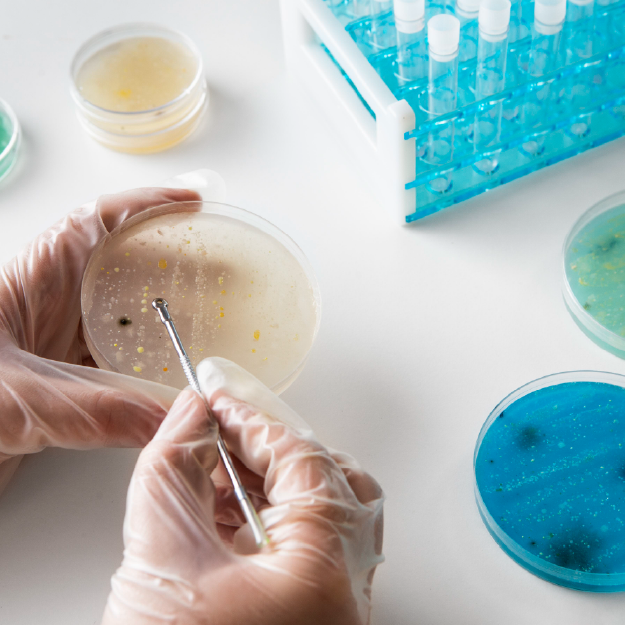
Laboratory petri dish with bacterial cultures

Space Microgravity Alters Virus-Bacteria Evolution, Offering New Hope for Phage Therapy
A groundbreaking study conducted aboard the International Space Station reveals that microgravity fundamentally changes how viruses and bacteria evolve during infection. Researchers from the University of Wisconsin-Madison found that bacteriophages and their E. coli hosts followed different evolutionary trajectories in space compared to Earth, accumulating unique genetic mutations. These space-driven adaptations have led to the engineering of phages with superior activity against drug-resistant pathogens, potentially revolutionizing treatments for antibiotic-resistant infections. The research demonstrates how space-based science can yield unexpected breakthroughs for terrestrial medicine.
The International Space Station has become an unlikely but powerful laboratory for medical discovery. In a pioneering experiment, scientists sent bacteria-infecting viruses, known as bacteriophages, to the orbiting laboratory to observe how microgravity alters their fundamental interactions. The results, published in PLOS Biology, reveal a surprising evolutionary divergence with profound implications for combating one of humanity's most pressing health threats: antibiotic-resistant infections.

The Space-Based Experiment: Phages vs. Bacteria in Microgravity
Researchers from the University of Wisconsin-Madison conducted a comparative study between two sets of E. coli samples infected with the T7 bacteriophage. One set remained on Earth under normal gravity conditions, while the other was incubated aboard the International Space Station. The goal was to understand how the absence of gravity's constant pull affects the microscopic arms race between viruses and their bacterial hosts.
In microgravity, the physical rules governing how phages encounter and attach to bacteria change dramatically. On Earth, gravity influences sedimentation and fluid dynamics, affecting how these microscopic entities collide. In the near-weightless environment of the ISS, these forces are absent, creating a fundamentally different battlefield for microbial warfare. The study, led by Phil Huss and colleagues, represents one of the most detailed examinations of phage-bacteria dynamics in space to date.
Divergent Evolutionary Paths in Space
The analysis revealed that while the T7 phage successfully infected E. coli in space after an initial delay, the evolutionary outcomes differed markedly from terrestrial controls. Whole-genome sequencing of both the viruses and bacteria exposed distinct genetic mutation patterns that emerged exclusively under microgravity conditions.
The space-station phages gradually accumulated specific mutations that appeared to enhance their infectivity and improve their ability to bind to receptors on bacterial cells. Meanwhile, the E. coli in space developed mutations that potentially offered better protection against phage attacks while also enhancing their survival in the unique near-weightless environment. This represents a clear case of coevolution—where both predator and prey adapt in response to each other—but following a trajectory unseen on Earth.

Engineering Superior Phages from Space Adaptations
The most significant breakthrough came when researchers applied a technique called deep mutational scanning to examine changes in the T7 phage's receptor binding protein—the key component that allows the virus to latch onto and infect bacterial cells. The microgravity-associated alterations in this protein were then tested back on Earth with remarkable results.
Phages engineered with these space-derived mutations demonstrated significantly increased activity against strains of E. coli that cause urinary tract infections in humans and are normally resistant to the T7 phage. This finding suggests that the evolutionary pressures of microgravity can drive phages to develop novel infection strategies that remain effective against drug-resistant pathogens in terrestrial environments.
Implications for Combating Antibiotic Resistance
The research arrives at a critical moment in global health. Antibiotic resistance has been declared a major threat by the World Health Organization, with an estimated 1.27 million deaths directly attributable to resistant infections in 2019 alone. Phage therapy—using viruses to target and kill specific bacteria—has emerged as a promising alternative, but its development faces challenges, including bacterial resistance to phages themselves.
This space-based research offers a novel approach to overcoming these limitations. By studying how phages evolve under the unique selective pressures of microgravity, scientists can identify evolutionary pathways and adaptations that might not emerge in Earth-based laboratories. These insights can then be harnessed to engineer next-generation phages with enhanced capabilities against resistant bacterial strains.
The Future of Space-Based Biomedical Research
The success of this experiment highlights the untapped potential of the International Space Station as a platform for biomedical innovation. The authors note in their published paper that "space fundamentally changes how phages and bacteria interact" and that studying these space-driven adaptations has yielded "new biological insights" with direct applications for human health.
This research opens doors to further investigations into how other microorganisms behave and evolve in space, with potential applications ranging from developing new antimicrobials to understanding how human pathogens might adapt during long-duration space missions. As commercial space stations become operational in the coming years, access to microgravity research environments may expand, accelerating discoveries at the intersection of space science and medicine.
Conclusion
The experiment aboard the International Space Station has demonstrated that the unique environment of microgravity serves as more than just a curiosity—it's a catalyst for evolutionary innovation at the microbial level. By sending viruses to space and observing their altered battle with bacteria, scientists have uncovered genetic adaptations that can be engineered into more effective phage therapies against drug-resistant infections. This research exemplifies how investment in space science can yield unexpected but vital returns for terrestrial medicine, offering new hope in the ongoing fight against antibiotic resistance. As we continue to explore space, we may find that some of the most valuable discoveries won't be about distant planets, but about the microscopic life we bring with us and how it changes in the final frontier.





